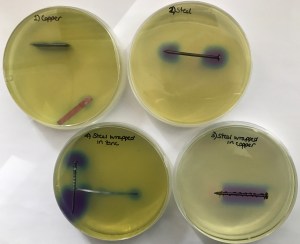
IMG_0121

Background
The corrosion of metals is an important research topic that has many applications. Metals can corrode in aqueous environments (in water), due to electrochemical processes, and these can be exploited by artists and architects to create colourful sculptures or buildings, including several copper-clad buildings and the Mermaid Fountain, at the University of Birmingham.
However, if the copper pipes that deliver water to our homes start to corrode, this can eventually result in the pipes bursting. It is also incredibly important to understand the chemical processes involved in metal corrosion for managing nuclear waste; we currently store by-products from nuclear power generation in metal containers in the ground or in storage ponds.
(photographs by N. J. Rogers Simpson)
Corrosion is a global issue that affects many industries that are vital to our everyday lives. To find out more about the global cost and impact of corrosion, take a look at the website for NACE International, the worldwide corrosion authority.
The way in which a metal dissolves electrochemically in solution is also important for the development of new batteries, in order to improve the power sources for portable electronic devices. As technology improves and we strive to do more and more with our smartphones and other wireless electronic devices, we need to develop better batteries to be able to keep up with more power-demanding technology.
Electrochemistry is a general title for the study of chemical reactions that involve ions in solution. To find out more about electrochemistry, take a look at the video below:
For more resources on electrochemistry, follow this link.
Experiment
A pdf version of this experiment is available here. Please ensure you refer to the safety card. Details for teachers or technicians can be found here.
AIM
To observe the corrosion of different metals, and understand the electrochemical processes at play
YOU WILL NEED
- Glass beaker and stirring rod or stirrer bar
- hot plate
- NaCl (s)
- agar
- universal indicator
- plastic petri dishes
- heat-protective gloves
- plastic pipette
- steel (steel nail)
- copper (sheet or wire)
- zinc foil cut into very thin strips, so that it can be wound around the steel
- fine sand paper
PROCEDURE
Sand down any metal samples with fine sandpaper, and wash and dry before using. Decide on which metal samples you wish to look at in each petri dish. It is a good idea to compare 1) copper, 2) steel, 3) steel wrapped in copper, and 4) steel wrapped in zinc. You can then choose what you wish to put in your remaining dishes. Prepare these samples and place them in the petri dishes.
Dissolve 6 g of salt in 200 mL tap water, and bring the solution to the boil. Slowly add 3 g of agar to the solution, whilst stirring. Heat with constant stirring until the agar has all dissolved. To test if the agar will set, pipette a small amount into a beaker, and make sure it forms a gel. Add 3-4 mL of universal indicator to the agar, and stir. Pour agar into 5-6 petri dishes, on top of the metal samples. Allow the dishes to cool and set without lids on (otherwise they will cover in condensation) and then put the lids on and label the samples.
Leave the samples for 1-2 days, and then observed what has happened.
Note for teachers: an alternative way to demonstrate this experiment with less time in the classroom is to pre-set the agar in the plates before the lesson, and students can push metal into the set agar. Agar can also be mixed with phenolphthalein indicator instead of universal indicator. The safety sheet for using pre-set agar plates can be found here, and the adapted student experiment sheet here.
QUESTIONS
- Draw what has happened to each of your samples, marking areas of blue/purple agar associated with reduction sites (cathode). Compare the steel sample to the copper sample – which reduces oxygen more easily?
- At the anode sites of the steel nail, oxidation of iron is occurring, initially to form Fe(II) ions. What happens to the agar at these sites? If you leave the dishes for several days you can see an orange/brown solid forming, what is this product?
- Compare the effect that copper and zinc have on the corrosion of the steel nail. Does the section of steel nail wrapped in copper/zinc corrode more or less in each case? How is this method used to protect metals from rusting?
- Why do you think we add salt to the agar to speed up the corrosion? (hint – what needs to move from the anode to the cathode?)
The electrochemistry at play:
The corrosion process occurs due to the metal oxidising, and forming ions in solution, but what is accepting the electrons and reducing?
Water cannot reduce to form hydrogen gas, unless the metal which is oxidising has a standard electrode potential (for the reduction of its ion to give the metal) that is more negative than -0.83 V. The species which is reducing in all of these systems is oxygen, which is dissolved in the water/agar gel. The oxygen reduces to form hydroxide ions, in the presence of copper, iron and zinc. Zinc is more reactive than iron, which is more reactive than copper, because zinc gives up its electrons to form Zn2+ more readily, and hence the standard reduction potential for Zn2+/Zn is more negative.

For the single steel nail embedded in agar, the agar starts to go blue/purple where the reduction is occurring, due to the formation of OH–, and this is the cathode (positive charge). At different sites on the nail, iron is oxidising to form Fe2+ and Fe3+, which form acidic complexes in water, and the agar will start to go orange/red. This indicates the anode sites.
Similar things are happening with the copper sample, although copper less-readily gives up its electrons, so the process is slower. It is also difficult to visualise the Cu2+ ions as they form initially, and the copper complexes are not very acidic.
The effect of joining two metals together within the agar is very interesting:
Zinc gives up its electrons more easily than iron, so it preferentially gives electrons to the oxygen, and also pushes electrons towards the iron, making the iron less likely to corrode. Copper, however, gives up its electrons less readily than iron, so it pulls electrons away from the iron, making it more likely to oxidise (corrode).
Architects, jewellers and artists often oxidise copper to make beautiful blue/green ‘patinas’ on the surface of metal surfaces, such as the Mermaid fountain (Birmingham, UK) and the Statue of Liberty (New York, USA). This is the same chemical process that causes corrosion. When the copper oxidises to form copper ions, these form complexes in solution that can vary in colour, depending upon what molecules (ligands) bind to them, i.e. [Cu(H2O)6]2+ is blue, [CuCl4]2- is green, [Cu(NH3)4(H2O)2] is a dark blue.
If you would like to make some corrosion art, follow this link, and please tweet us photos of your results @chembameditor #corrosionart.
Going Further
In many electrochemical experiments, it is easy to assume that the total flow of charge within the electrolyte is distributed uniformly, across the whole electrode surface- but is this actually true? And how can we find out what is happening within a battery, whilst it is in use? To examine the electrode surfaces of a battery we really need to open it up because we can’t see inside the opaque material, and this is not only destructive, but also potentially quite dangerous.
The way in which a metal ions transport and undergo electrochemistry within a battery is also very important for the development of new improved batteries, and therefore it is useful to be able to study the chemical processes that occur within a battery, without opening it up or breaking it.
In the research lab

In hospitals it is possible to image what is going on inside the body of a patient without cutting them open, using techniques such as X-Ray imaging and MRI (Magnetic Resonance Imaging). In a similar fashion, researchers in the School of Chemistry at the University of Birmingham use MRI to look at the way that metal ions move inside a battery, without destroying it. Researchers working with Dr Melanie Britton have successfully used MRI to image the electrochemical generation and transport of metal ions in solution, non-invasively. This research has demonstrated that the concentration of Cu2+ ions in the test system is not uniform across the length of the anode, and provides important insights into electrochemical processes that can be applied to other processes. To find out more about this group’s research click here.
Publication of research relating to corrosion chemistry

To access the above paper, click here.
Documents to download
pdf files:
Corrosion experiment guide for students
Corrosion experiment guide for students, using pre-plated agar
Corrosion experiment safety card
Corrosion experiment safety card, using pre-plated agar
Corrosion experiment guide for technicians
Corrosion experiment guide for teachers
editable files:
Corrosion experiment guide for students word document
Corrosion experiment, using pre-plated agar word document

This work is licensed under a Creative Commons Attribution 4.0 International License.